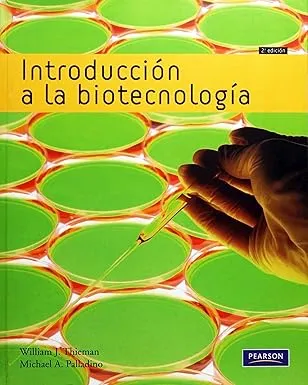
Introducción a la Biotecnología

Introducción a la Biotecnología
| Expone los principios básicos y aplicaciones modernas de la biotecnología en salud, agricultura e industria. |
-
ISBN
-
Autores
-
Editorial
Términos y condiciones
Envío: Una vez realizado el pago en el campus que seleccionó, la entrega será aproximadamente de 7 a 10 días hábiles, según disponibilidad logística.
Monto: Cada estudiante cuenta con un límite de consumo de L 2,500.00 por persona. Este monto puede utilizarse en una sola compra o dividirse en varias compras hasta completar el total asignado, caso contrario si excede al monto de L 2,500.00 su orden será cancelada.
Envío: Una vez realizado el pago en el campus que seleccionó, la entrega será aproximadamente de 7 a 10 días hábiles, según disponibilidad logística.
Monto: Cada estudiante cuenta con un límite de consumo de L 2,500.00 por persona. Este monto puede utilizarse en una sola compra o dividirse en varias compras hasta completar el total asignado, caso contrario si excede al monto de L 2,500.00 su orden será cancelada.
| ISBN: 9788478291175 |
| Autores: William J Thieman |
| Editorial: Pearson |